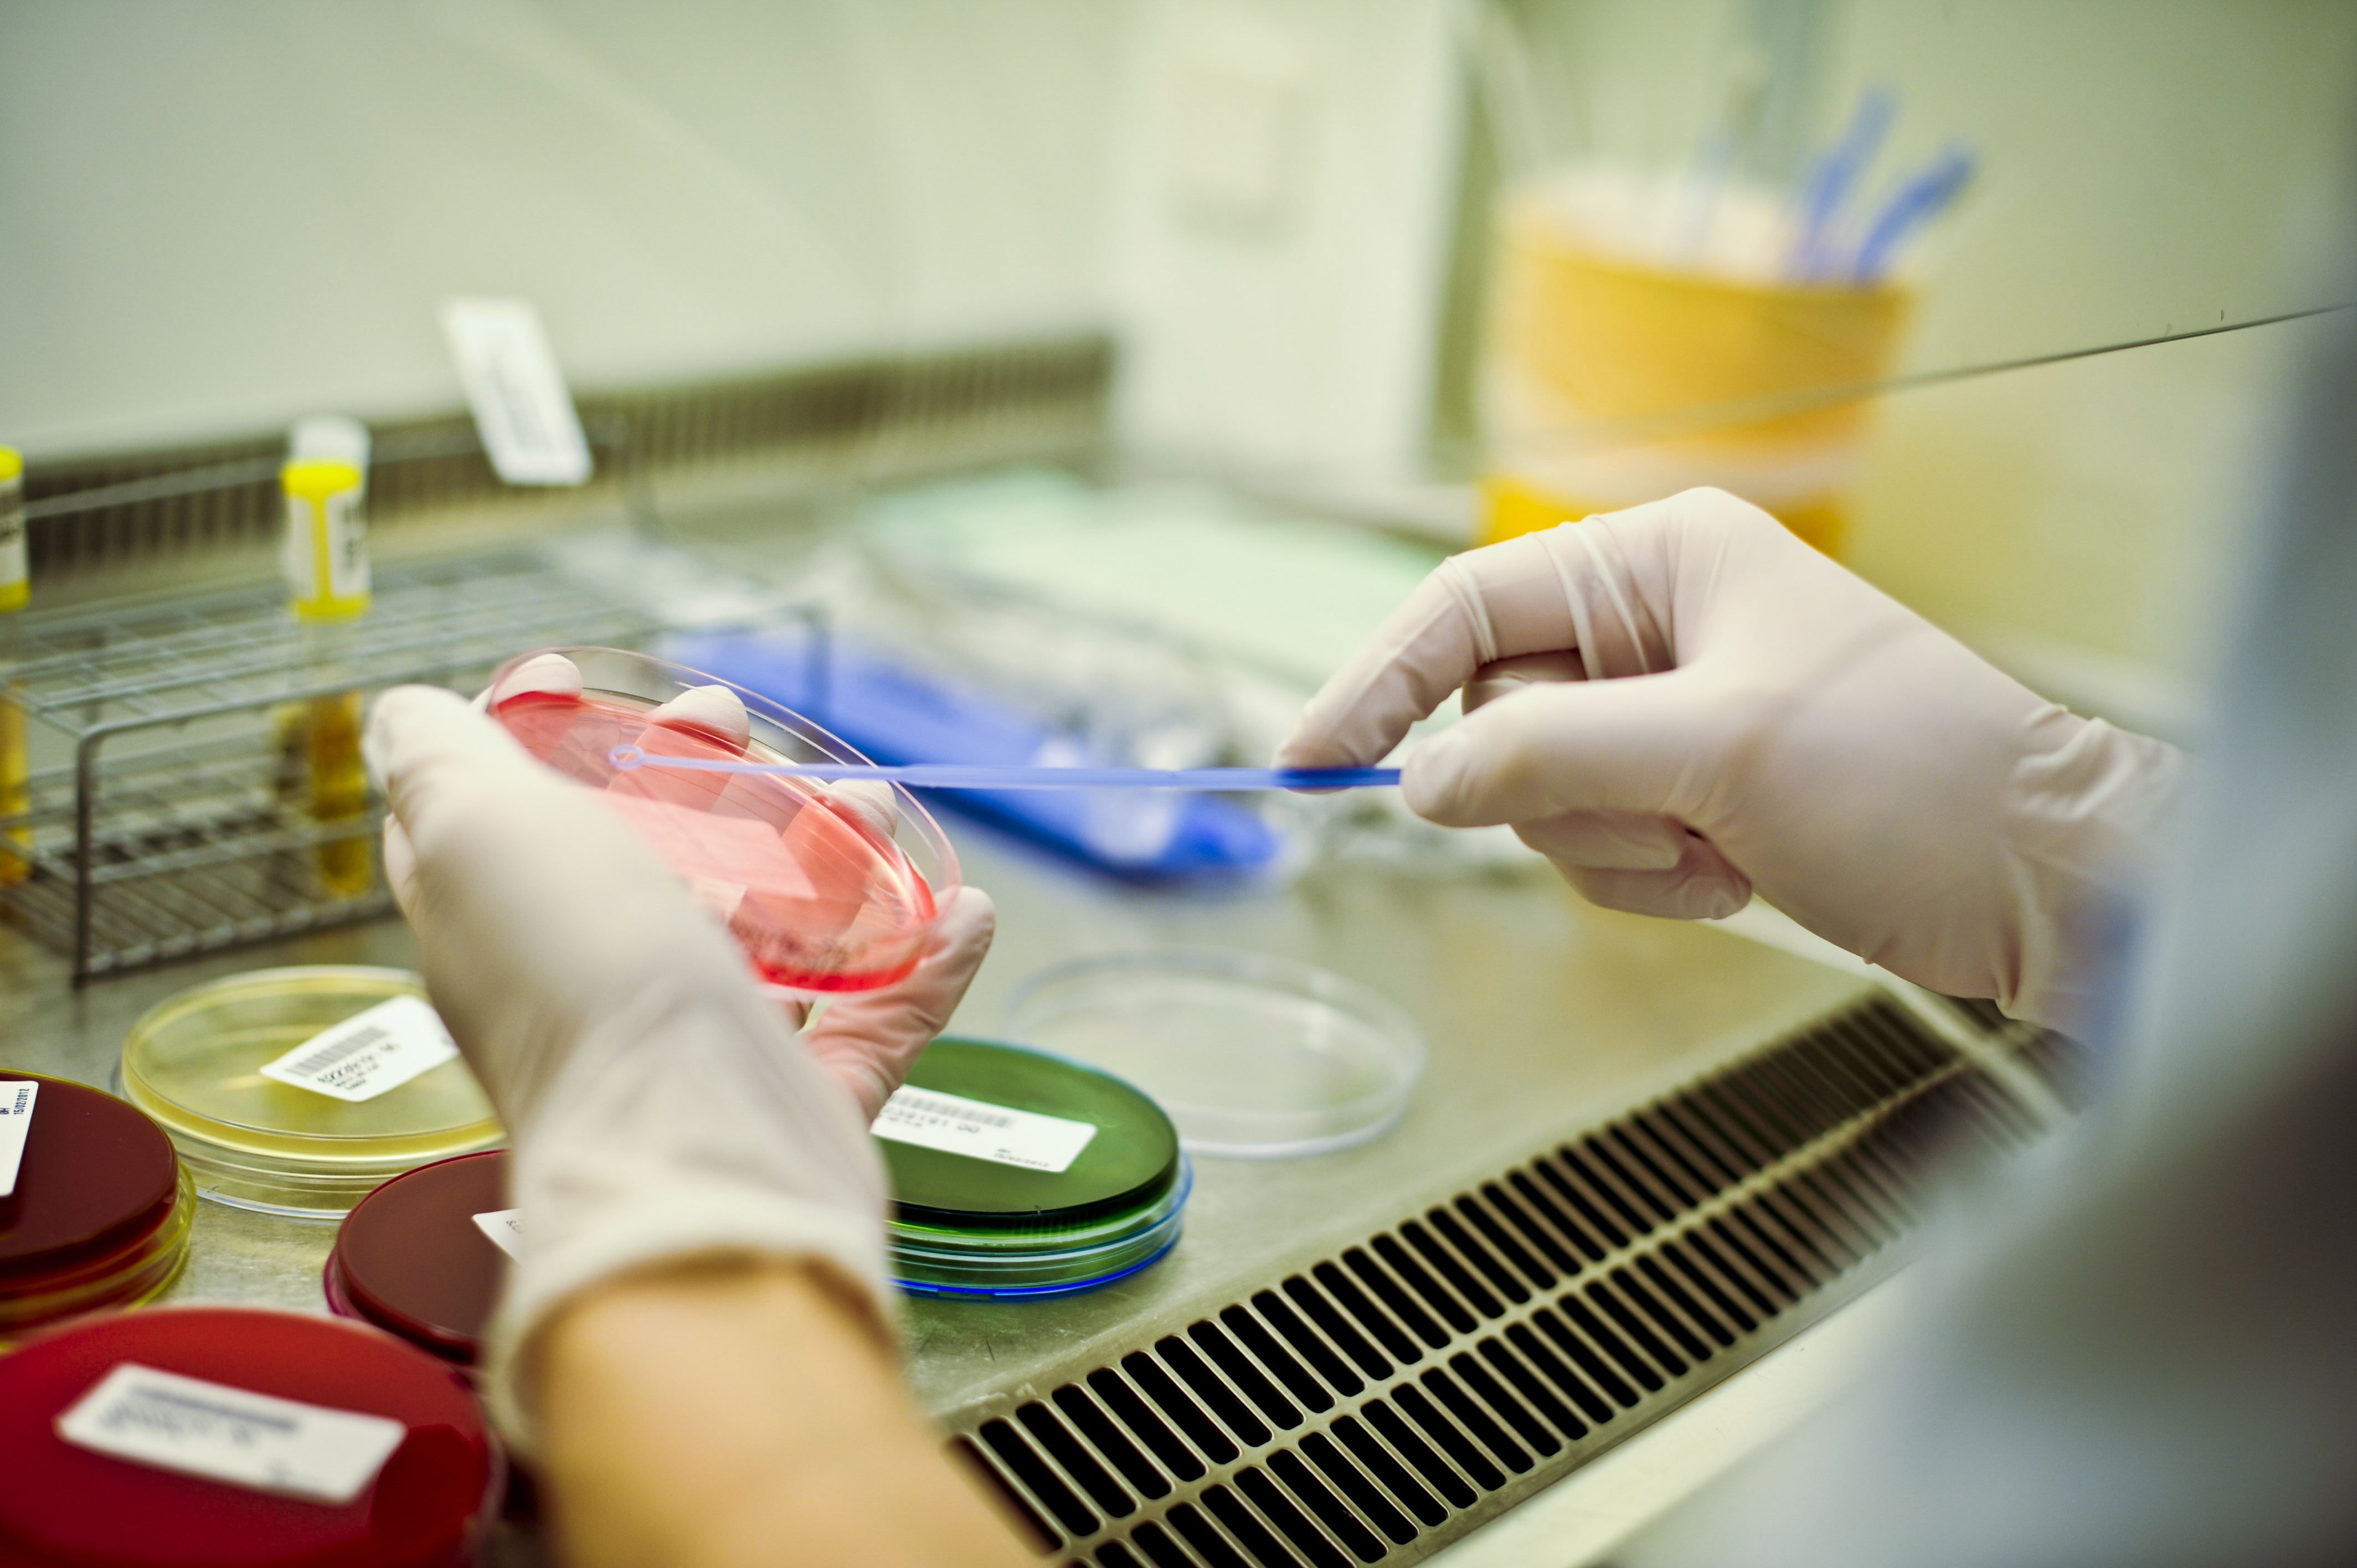
Laboratorieprøver. Foto

I foajeen i Sentralblokka på Haukeland finn du eit apotekutsal for publikum. Dei gjer klar resepten din medan du ventar der.
Meir informasjon om sjukehusapoteket i Sentralblokka
Opningstider
Måndag-fredag kl. 08.30-17.00
Telefon 55 97 53 44
Telefaks 55 29 07 40
bergen@apotekene-vest.no
Apotekutsalet har eit variert varetilbod, og fører dei legemidla sjukehuset nyttar i behandlinga. Dei skaffar også legemiddel som ikkje er marknadsførte i Noreg eller som må produserast spesielt. I tillegg har dei hudpleie- og hygieneartiklar og ernæringsprodukt, samt andre apotekvarer og sjukepleieartiklar.
Dei ansatte ved apoteket gir deg informasjon, råd og rettleiing om legemiddel og legemiddelbruk og kan tilby samtale/rettleiing mellom personale og pasient på eit uforstyrra samtalerom. Dei tilbyr og opplæring i blodsukkermåling og bruk av inhalasjonspreparat.
Apoteket tar også i mot gamle legemiddel til destruksjon.
Du kan betale med Vipps på apoteket. Du kan derfor mellom anna betale på førehand når du skal hente bestilte medisinar.